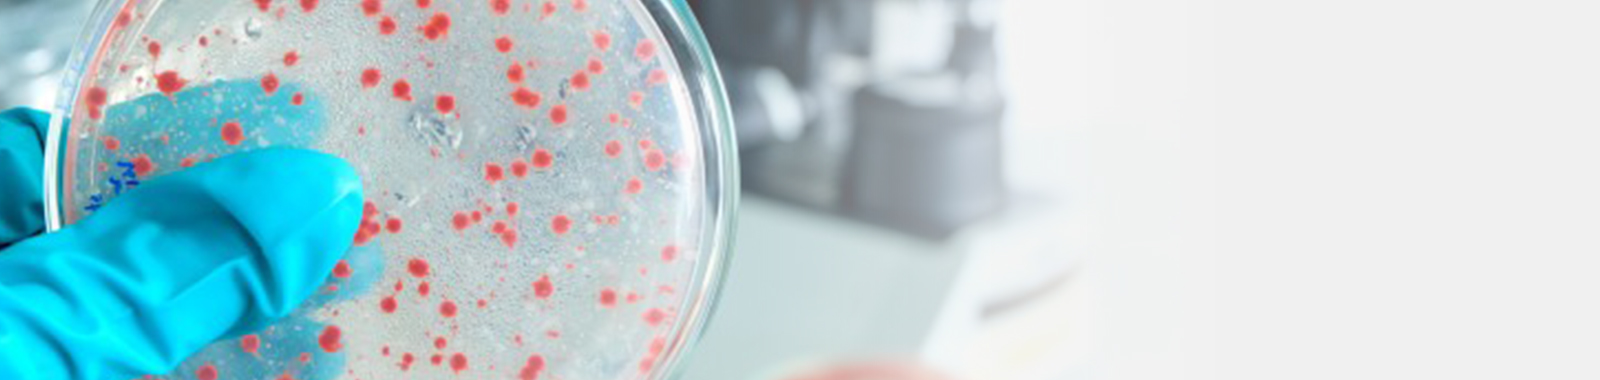

Time-Kill & Rapid Germicidal Activity Studies
Global expertise, personal touch
Proving How Fast Your Product Works
A Time-Kill study is designed to answer a different, more immediate question: how quickly and effectively does an antimicrobial product kill microorganisms? This in vitro suspension test provides critical data on the rate and extent of microbial reduction over very short timeframes, such as 15 seconds, 30 seconds, or 1 minute.
Purpose
The primary purpose of a Time-Kill study is to measure the rapid germicidal activity of a formulation against specific microorganisms in suspension. The test involves exposing a standardised population of a target microorganism (e.g., Staphylococcus aureus) to the antimicrobial efficacy test product. At predetermined, short time intervals, samples are taken, the antimicrobial action is neutralised, and the surviving organisms are enumerated. The results are then used to calculate the log reduction at each time point, providing a clear picture of the product's kill rate.
Application: Substantiating Marketing Claims
The data generated from Time-Kill testing is essential for substantiating the specific, powerful, and time-sensitive marketing claims that are prevalent in the antimicrobial efficacy testing and product space. For R&D teams, it provides invaluable data for optimising formulations to achieve rapid efficacy. For marketing teams, it delivers the scientific proof required to make compelling, data-backed claims that resonate with consumers and meet advertising standards, such as:
- "Kills 99.9% of germs in 15 seconds."
- "Rapidly eliminates bacteria on contactt"
- "Fast-acting antimicrobial form.la"
This testing is particularly critical for products like hand sanitisers, antimicrobial soaps, and surface disinfectants, where speed of action is a key performance attribute and a major consumer expectation.
FAQs
Q1: What is a Time-Kill study in antimicrobial testing?
A Time-Kill study measures how quickly and effectively an antimicrobial product kills microorganisms in short timeframes. It provides critical data for antimicrobial preservative efficacy test results.
Q2: How is a Time-Kill study different from a standard antimicrobial efficacy test?
A Time-Kill study focuses on the speed and rate of microbial reduction over short contact times (e.g., 15, 30, or 60 seconds), showing how fast a product works. In contrast, a standard antimicrobial efficacy test (AET) evaluates the overall effectiveness of a product over longer periods or under simulated use conditions. Time-Kill testing is ideal for demonstrating rapid germicidal performance, while AET confirms sustained antimicrobial efficacy.
Q3: What is antimicrobial efficacy testing AET used for?
Antimicrobial efficacy testing AET is used to substantiate product claims such as “kills 99.9% of germs in 15 seconds” for hand sanitisers, soaps, and surface disinfectants.
Q4: How is microbial reduction measured in a Time-Kill study?
The product is exposed to a standardised microbial population, and surviving organisms are enumerated at predetermined intervals. Log reductions are calculated to determine the product’s rapid antimicrobial efficacy.
Q5: Why is Time-Kill testing important for marketing claims?
Time-Kill data provides scientific proof to support rapid-acting claims, helping products meet advertising standards and consumer expectations. It also guides R&D for optimising formulation speed and effectiveness.